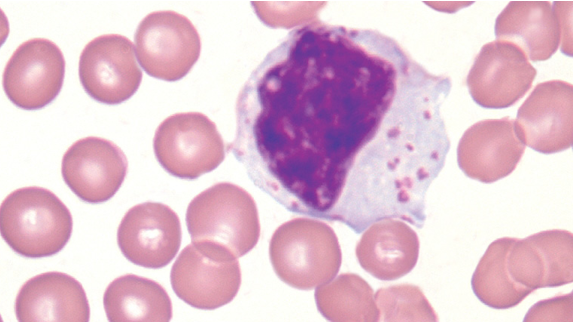
<p>what type of cell is this that contains Azorophilic granules?</p>
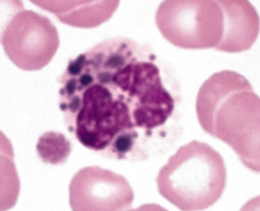
<p>What is the causation and presentations of the Chediak Higashi syndrome?</p>
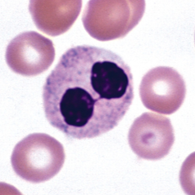
<p>What is the classification, causation, and characteristics of pelger huet anomaly (PHA)?</p>

leukocytes & non-malignant leukocyte disorders
1/35
There's no tags or description
Looks like no tags are added yet.
Name | Mastery | Learn | Test | Matching | Spaced | Call with Kai |
|---|
No analytics yet
Send a link to your students to track their progress
36 Terms
what are granulocytes? Name 3
A group of leukocytes that have granules in their cytoplasm and have a segmented nucleus.
eosinophils
neutrophils (PMN’s)
basophils
What cells come from the myeloid progenitor?
granulocyte-monocyte progenitor
megakaryocyte progenitor
Erythrocyte progenitor
What cells come from the lymphoid progenitor?
All lymphocytes
Dendritic cell
B cells (B helper cells)
T cells (T killer cells)
NK killer cells
Put the following in order according to neutrophil maturation:
segmented neutrophil
myeloblast
band
promyelocyte
myelocyte
metamyelocyte
myeloblast
promyelocyte
myelocyte
metamyelocyte
band
segmented neutrophil

What is this cell according to neutrophil maturation and where would you see it?
myeloblast in bone marrow
What characteristics would you see in a myeloblast?
slightly basophilic cytoplasm
fine granular chromatin
two to four visible nucleoli

What is this cell according to neutrophil maturation and where would you see it?
promyelocytes in the bone marrow
What characteristics would you see in a promyelocyte?
nucleus is round to oval and is eccentric.
a paranuclear halo or “hof” is seen
cytoplasm is evenly basophilic and full of primary azurophilic granules.
pneumonic: what does the p for promyelocyte stand for?
It stands for primary azurophilic granules
what are the primary granules from a promyelocyte made up of?
myeloperoxidase
acid b-glycerophosphatase
cathepsins

What is this cell according to neutrophil maturation and where would you see it?
myelocyte seen in bone marrow
What characteristics would you see in a myelocyte?
cells have secondary granules
secondary neutrophilic granules spread throughout the cell until it is more lavender-pink than it is blue

What is this cell according to neutrophil maturation and where would you see it?
metamyelocyte normally seen only in the bone marrow
What characteristics would you see in a metamyelocyte?
nucleus starts to indent and looks like a kidney bean shape or peanut shaped
chromatin is increasingly clumped
tertiary granules may begin to appear
what is the difference between banded and segmented neutrophils?
presence of 2-5 nuclear lobes in segmented neutrophils
B lymphocytes develop in the ___.
Bone marrow
T lymphocytes develop in the _____.
Thymus
what type of cell is this that contains Azorophilic granules?
Activated NK cell
What is the classification, causation, and presentations of the Wiskott-aldrich syndrome?
Classification: combine immunodeficiency disorder
Causation: X-linked disease by mutation in the WAS gene —> decrease in WASp protein
Presentation: neutrophils and monocytes are dysfunctional which leads to bacterial and fungal infections
What is the causation and presentations of the Chediak Higashi syndrome?
causation: mutation in the CHS1 LYST gene on chromosome 1q42.1-2 that regulates the morphology and function of lysosome related organelles
presentation:
cells exhibit giant lysosomal fused granules
fused granules result in leukocyte dysfunction
patients often have bleeding issues and recurrent pyogenic infections
What is the classification, causation, and characteristics of pelger huet anomaly (PHA)?
classification: true or congenital PHA is an autosomal dominant disorder
causation: mutation in the lamin B receptor
Characteristics:
decreased nuclear segmentation (bilobed/unilobed)
coarse chromatin clumping pattern
seen in neutrophils and leukocytes
needs to be 70-80% in peripheral blood to be pelger huet
What is the cause and morphology of Alder-Reilly anomaly?
Cause: transmitted as a recessive trait
Morphology: granulocytes with large, darkly staining metachromatic cytoplasmic granules composed primarily of partially digested monopolysaccharides.

What is the classification, cause, and morphology of may-hegglin anomaly?
classification: a rare autosomal dominant platelet disorder
cause: a mutation in the MYH9 gene on chromosome 22q12-13
morphology:
variable thrombocytopenia
giant platelets
large dohle body-like inclusions in neutros, baso, eos, and mono
Seen in septic patients

What is the classification, cause, and morphology of Gaucher disease?
classification: most common lysosomal lipid storage disease
cause: defect/deficiency in the catabolic enzyme b-glucocerebrosidase (gene located at Iq21), which is necessary for glycolipid metabolism.
morphology: bone marrow contains gaucher cells, macrophages occuring individually or in clusters, that have an abundant fibrillar blue-gray cytoplasm with striated or wrinkled appearance.

What is the classification, characterization, and morphology of Niemann-pick disease?
classification: an autosomal recessive lipid storage disease
Characterization: type a and b are identified by the recessive mutations in the SMPD1 gene, which leads to a deficiency in the lysosomal hydrolase enzyme acid (sphingomyelinase ASM)
morphology: macrophages with a foamy cytoplasm packed with lipid-filled lysosomes that appear as vacuoles after staining bone marrow aspirate
What does leukomoid reaction mean?
reactive leukocytosis above 50×10^9 L with neutrophilia and a marked left shift (presence of immature neutrophilic forms). It is non-malignant.
what does leukoerythroblastic reaction mean?
the presence of immature neutrophils, nucleated RBCs, and teardrop RBCs
What is the formula for absolute neutrophil count (ANS)?
(WBC) x total neutrophils (segs% + bands%) x 10 = ANS
What is the one test that would help distinguish leukomoid reaction from chronic myeloid leukemia?
Leukocyte alkaline phosphatase (LAP score) would be elevated for leukomoid reaction but would be decreased for chronic myeloid leukemia
What is neutropenia and what does it cause?
It is the decrease in the absolute neutrophil count (ANC) and it raises the risk of severe infections. Two forms of getting neutropenia: acquired (drugs) and immune
What are some causes of non-malignant lymphocytosis?
infectious mononucleosis
hepatitis
acute HIV infection
chicken pox
or just viruses

What are dohle bodies, in which cells are they found, and what do they look like?
Dohle bodies are cytoplasmic inclusions consisting of remnants of ribosomal ribonucleic acid (RNA).
typically found in neutrophils that often contain toxic granulation
they appear in the cytoplasm as pale blue round or elongated bodies.
What does toxic granulation of neutrophils look like?
toxic granulation appears as dark, blue-black granules in the cytoplasm
associated w/ infection
a lot of granules but not pack the cytoplasm
when is vacuolation of neutrophils seen?
seen in septic patients caused by either bacteria or fungi
what are some clinical manifestations and cause of infectious mononucleosis?
cause: by epstein-barr virus (EBV)
manifestations:
sore throat, dysphagia, fever, chills, cervical lymphadenopathy, fatigue, and headache
WBC elevated or with absolute lymphocytosis
reative changes in lymphocytes that would indicate infectious mononucleosis
reactive lymph with nucleioli in the nucleus
soccer ball appearance of nucleus